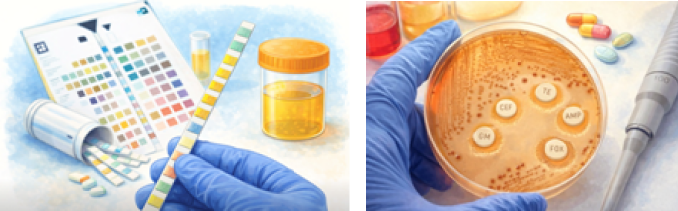

Инфекции мочевыводящих путей (ИМП) часто встречаются у детей. К 5-летнему возрасту примерно у 8% девочек и у 1–2% мальчиков возникает как минимум один эпизод ИМП.
У детей старшего возраста ИМП могут проявляться типичными симптомами, такими как жжение или боль при мочеиспускании. У младенцев и детей раннего возраста выявление инфекции затруднено, поскольку симптомы носят неспецифический характер. Иногда единственным признаком может быть лихорадка (повышение температуры).
Большинство ИМП возникают вследствие бактериального инфицирования мочевыводящих путей. Инфекция может локализоваться на любом уровне, однако чаще поражается нижний отдел — уретра и мочевой пузырь. Это состояние называется уретритом или циститом. При распространении инфекции по мочеточникам к почкам развивается пиелонефрит, который протекает тяжелее.
В норме моча стерильна, однако бактерии могут легко проникать в мочевые пути с кожи перианальной области (кишечная палочка Escherichia coli является наиболее частой причиной ИМП). Реже инфекцию вызывают другие бактерии и некоторые вирусы. В отдельных случаях микроорганизмы могут попадать в мочевой пузырь или почки гематогенным путём. Бактериальные ИМП не являются заразными.
ИМП значительно чаще встречаются у девочек, что связано с более короткой уретрой и её близостью к анальному отверстию. У необрезанных мальчиков младше 1 года риск также несколько повышен.
ИМП хорошо поддаются лечению, однако крайне важно раннее выявление. Несвоевременно диагностированные или нелеченные инфекции могут привести к повреждению почек.
Симптомы зависят от возраста ребёнка и локализации инфекции.
У младенцев и маленьких детей:
У детей старшего возраста:
При цистите:
При пиелонефрите:
После осмотра и оценки симптомов врач назначает анализ мочи для выявления возбудителя.
Метод получения образца зависит от возраста:
Проводятся:
У части детей, особенно раннего возраста или при рецидивах, требуется дополнительное обследование для исключения аномалий мочевыводящих путей:

ИМП лечатся антибиотиками. Выбор препарата и длительность терапии зависят от возбудителя и тяжести инфекции.
Через несколько дней лечения может быть выполнен повторный анализ мочи для подтверждения эрадикации инфекции и уменьшения симптомов воспаления.
Рекомендации:

Неосложнённый цистит обычно лечится амбулаторно пероральными антибиотиками, фитопрепаратами.
При тяжёлом течении может потребоваться госпитализация и внутривенное введение антибиотиков, особенно при наличии обструкции или пузырно-мочеточникового рефлюкса.
Материал подготовлен при содействии Российского общества детских урологов-андрологов (РОДУА)
*При копировании любой части материала любым способом требуется письменное разрешение РОДУА